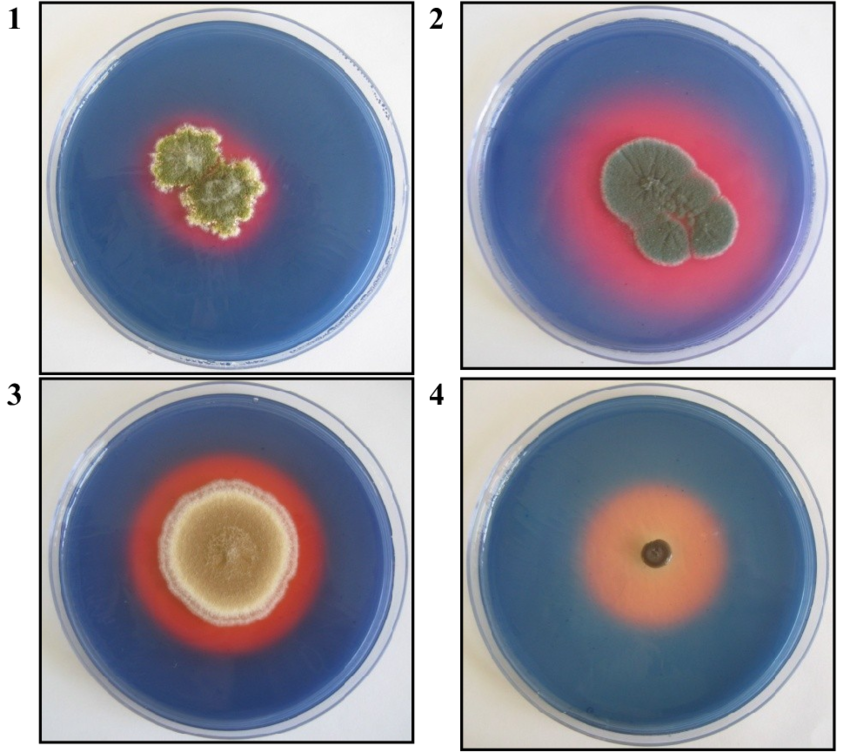

Pseudallescheria et Scedosporium :
champignons opportunistes résistants aux traitements antifongiques
Les champignons Pseudallescheria et Scedosporium sont aujourd’hui reconnus comme des agents pathogènes émergents responsables d’infections graves, notamment chez les patients immunodéprimés. Ces infections sont souvent difficiles à diagnostiquer et à traiter, en raison d’une forte résistance aux antifongiques et d’une grande diversité génétique.
Pourquoi ces champignons représentent-ils une menace croissante ?
- Leur capacité à survivre dans des environnements pollués favorise l’apparition de souches plus virulentes.
- Ils peuvent coloniser les poumons de patients atteints de mucoviscidose ou de cancers hématologiques.
- Leurs symptômes ressemblent souvent à ceux d’autres infections fongiques, ce qui complique leur détection.
Diagnostic et surveillance clinique
L’un des plus grands défis est leur identification précise. Ces champignons peuvent être confondus avec Aspergillus en histopathologie ou en culture. Les méthodes de diagnostic moléculaire et sérologique sont donc essentielles pour éviter les erreurs.En savoir plus
Les études de surveillance permettent de mieux comprendre la fréquence, les modes de transmission et les conditions environnementales favorisant leur apparition.
Recherche et nouvelles thérapies
Les scientifiques travaillent activement à :
- Identifier les facteurs de virulence responsables de l’invasion des tissus,
- Développer de nouveaux antifongiques ciblés,
- Mettre au point des modèles animaux pour tester l’efficacité thérapeutique,
- Créer une banque de données européenne regroupant les souches et les profils de résistance.
Transmission et environnement
Ces champignons sont souvent présents dans des sols contaminés, des boues et des zones à forte pollution azotée. Leur évolution dans ces milieux pourrait expliquer leur adaptation progressive à l’homme et leur résistance accrue aux traitements.
Un enjeu de santé publique
La compréhension de la biologie et de la pathogénicité de Pseudallescheria / Scedosporium est essentielle pour développer des protocoles de diagnostic rapide et des stratégies thérapeutiques efficaces.
Grâce à la collaboration entre laboratoires, institutions médicales et chercheurs, une approche globale de surveillance et de prévention peut être mise en place pour limiter leur impact sur la santé humaine.